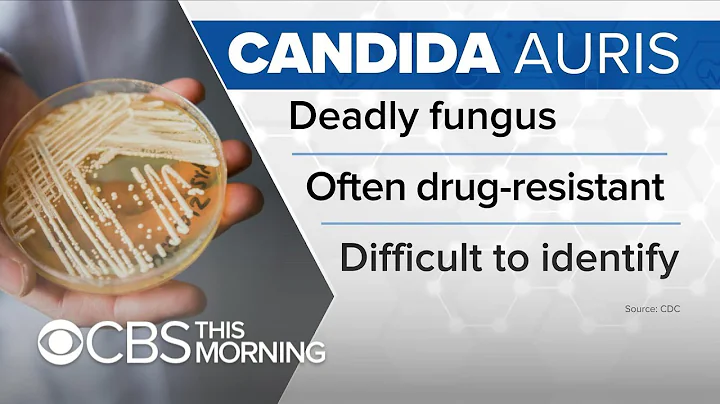

Candida J Crane
age ~58
from Seattle, WA
- Also known as:
-
- Candida Johns Crane
- Candida Michelle Crane
- Candida M Crane
- Candida J C Johns
- Candida J Johns
- Candida M Johns
- Cindid M Crane
- Candida J Wesley
- A Crane
- Johns Candida
- Phone and address:
-
4111 Evanston Ave, Seattle, WA 98103
(206)5472657
Candida Crane Phones & Addresses
- 4111 Evanston Ave, Seattle, WA 98103 • (206)5472657
- Leavenworth, WA
- 1412 2Nd St, Kirkland, WA 98033 • (425)5760290
- Clyde Hill, WA
Work
-
Company:Rosa parks elementaryAug 2012
-
Position:School counselor, lake washington school district
Education
-
School / High School:Seattle University- Seattle, WAJun 2003
-
Specialities:Leadership Institute for Counselors
Skills
Certified School Counselor with the Stat... • over 350 training hours in Mental Health...
Resumes

Candida Crane
view sourceLocation:
Seattle, WA
Industry:
Primary/Secondary Education
Work:
Lake Washington School District Aug 2002 - Jun 2016
School Counselor
Community Psychiatric Clinic 1993 - 2002
Case Manager
School Counselor
Community Psychiatric Clinic 1993 - 2002
Case Manager
Education:
Western Washington University 1998 - 2000
Master of Education, Masters, Psychology
Master of Education, Masters, Psychology

Candida Crane Seattle, WA
view sourceWork:
Rosa Parks Elementary
Aug 2012 to 2000
School Counselor, Lake Washington School District Einstein Elementary, School
Redmond, WA
Aug 2002 to Jun 2012
School Counselor, Title I School, Lake Washington School District Redmond High School
Jun 2009 to Aug 2009
Summer School Teacher Assistant/Counselor, Paul Spoor Briarcrest Elementary
Shoreline, WA
Aug 2003 to Jun 2004
Family Advocate, Shoreline School District Community Psychiatric Clinic
Seattle, WA
Nov 2001 to Aug 2002
Residential Case Manager North Seattle Community College
Seattle, WA
Sep 2000 to Sep 2001
GED Program Coordinator and Vocational Advisor Community Psychiatric Clinic
Seattle, WA
Oct 1996 to Aug 2000
Primary Service Coordinator
Aug 2012 to 2000
School Counselor, Lake Washington School District Einstein Elementary, School
Redmond, WA
Aug 2002 to Jun 2012
School Counselor, Title I School, Lake Washington School District Redmond High School
Jun 2009 to Aug 2009
Summer School Teacher Assistant/Counselor, Paul Spoor Briarcrest Elementary
Shoreline, WA
Aug 2003 to Jun 2004
Family Advocate, Shoreline School District Community Psychiatric Clinic
Seattle, WA
Nov 2001 to Aug 2002
Residential Case Manager North Seattle Community College
Seattle, WA
Sep 2000 to Sep 2001
GED Program Coordinator and Vocational Advisor Community Psychiatric Clinic
Seattle, WA
Oct 1996 to Aug 2000
Primary Service Coordinator
Education:
Seattle University
Seattle, WA
Jun 2003
Leadership Institute for Counselors City University
Seattle, WA
2000
Master of Education in Guidance and Counseling Western Washington University
1990
B.A. in Psychology
Seattle, WA
Jun 2003
Leadership Institute for Counselors City University
Seattle, WA
2000
Master of Education in Guidance and Counseling Western Washington University
1990
B.A. in Psychology
Skills:
Certified School Counselor with the State of Washington, over 350 training hours in Mental Health Counseling for all ages.

School Counselor At Lake Washington School District
view sourcePosition:
School Counselor at Lake Washington School District
Location:
Greater Seattle Area
Industry:
Primary/Secondary Education
Work:
Lake Washington School District
School Counselor
School Counselor
Youtube
Get Report for Candida J Crane from Seattle, WA, age ~58